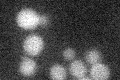
YOR213C
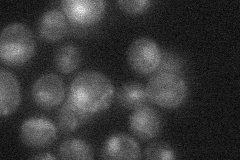
YOR213C
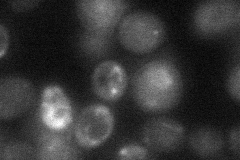
YOR213C
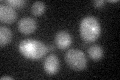
YOR213C
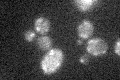
YOR213C

View description
Subunit of the SAS complex (Sas2p, Sas4p, Sas5p), which acetylates free histones and nucleosomes and regulates transcriptional silencing; stimulates Sas2p HAT activity
Localization:
Intensity:
Fold change:
Significance:
-
C’ GFP library in SD
below threshold16.64 -
N' NOP1pr-GFP in SD

nucleus37.3712 -
N' TEF2pr-mCherry in SD

nucleus14.4511 -
N' NATIVEpr-GFP in SD
nucleus23.8132 -
N' TEF2pr-VC and Cyto-VN in SD
below threshold25.1876 -
C’ GFP library in SD+DTT
cytosol16.891.01No -
C’ GFP library in SD+H2O2
cytosol15.970.95No -
C’ GFP library in Starvation Media

cytosol15.290.91No -
C’ GFP library on the background of Pup2-DaMP

below threshold -
C’ GFP library on the background of CCT mutant

below threshold17.59811.05686No
